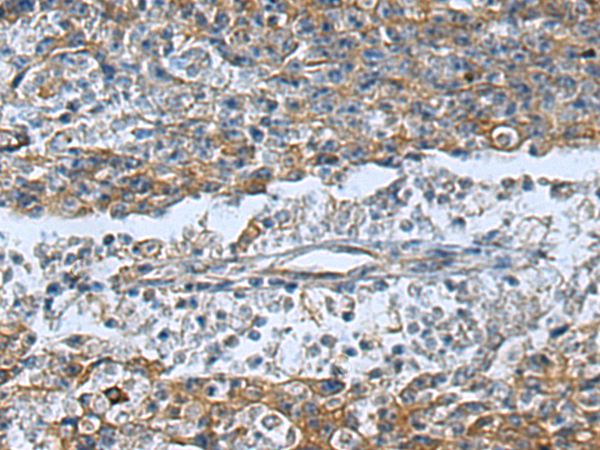

-
分类: 科研抗体货号: P05636别名: CD370; DNGR1; DNGR-1; UNQ9341应用: WB反应种属: Human
-
分类: 科研抗体货号: P05625别名: APH-1; APH-1A; CGI-78; 6530402N02Rik应用: IHC反应种属: Human, Mouse
-
分类: 科研抗体货号: P05687别名: CD299; LSIGN; CD209L; L-SIGN; DCSIGNR; HP10347; DC-SIGN2; DC-SIGNR应用: IHC反应种属: Human
-
分类: 科研抗体货号: P05624别名: ALDM; ALDHI; ALDH-E2应用: WB,IHC反应种属: Human, Mouse, Rat
-
分类: 科研抗体货号: P05682别名: D2R; D2DR应用: IHC反应种属: Human, Mouse, Rat
-
分类: 科研抗体货号: P05622别名: HHT; ALK1; HHT2; ORW2; SKR3; ALK-1; TSR-I; ACVRLK1应用: WB,IHC反应种属: Human
-
分类: 科研抗体货号: P05678别名: CCNG应用: WB,IHC反应种属: Human, Mouse, Rat
-
分类: 科研抗体货号: P05621别名: FIGF; VEGF-D应用: IHC反应种属: Human
-
分类: 科研抗体货号: P05668别名:应用: WB,IHC反应种属: Human, Mouse, Rat
-
分类: 科研抗体货号: P05615别名: CNR2; CNRN2; CNRS2; CRNR2; PCDH-ALPHA6应用: IHC反应种属: Human

鄂公网安备42018502007531号
鄂公网安备42018502007531号

